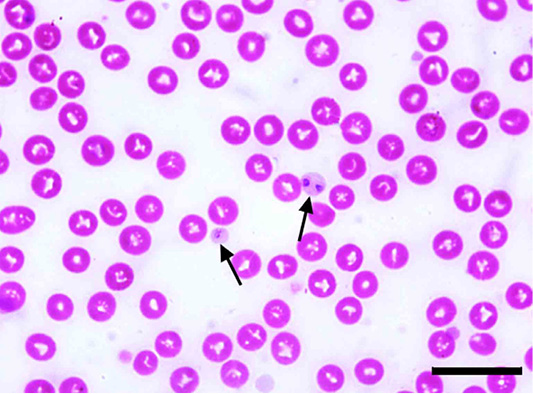
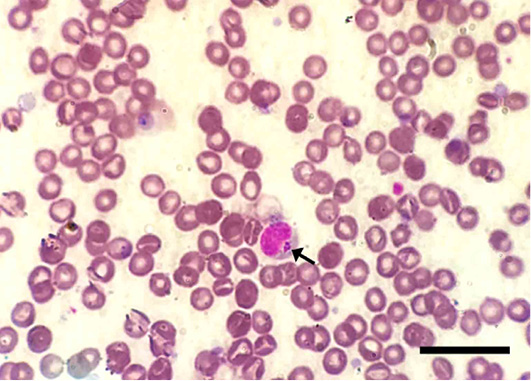

Advances in Animal and Veterinary Sciences
Anaplasma platys inclusion bodies in blood platelets (arrows) of Giemsa-stained blood smear of an infected dog. Scale bar= 20 um.
Ehrlichia canis inside a macrophage in Giemsa-stained blood smear of an infected dog. Note the multiple, relatively large-sized and round-shaped morulae intracellularly (arrows). Scale bar= 20 um.
The adult brown tick, Rhipicephalus sanguineus, infesting the surveyed dogs. a) A dog ear infested with the tick vector. b) Doral view of the adult tick. c) Anteroventral view of the adult tick. d) Posterventral view of the adult tick. Scale bar= 0.5 mm.
PCR amplification of DNA extracted from blood of surveyed dogs targeting the 16S rRNA gene using a primer specific for Anaplasma/Ehrlichia spp. Lane M: a ladder of 100 bp. Lanes 1,2 showed control negative and control positive respectively. Lanes 3–12 showed 10 blood samples positive for Anaplasma/Ehrlichia spp. with a product of an amplicon size 345 bp.